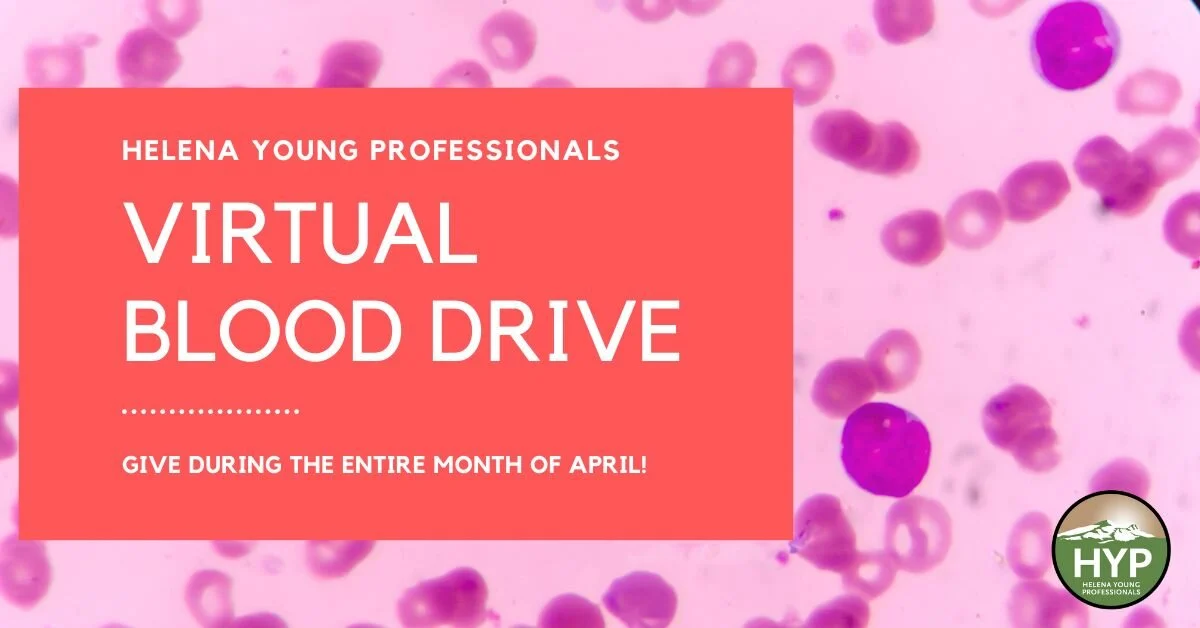

Looking for some way to help out during this crisis? Need a (socially responsible) excuse to get out of the house? Take part in our HYP Virtual Blood Drive! While social distancing measures are now in effect, the need for blood has not gone away. The Red Cross cancelled many group blood drives and are relying on donations made at local donation centers for the foreseeable future. If you’re feeling healthy and helpful, pledge to donate here. The link will take you to the scheduling app with available appointments. Be sure to complete your rapid pass prior to your appointment to keep your time at the facility to a minimum. If you have questions please contact the donation center at 1-800-RED CROSS.
"Donating blood products is essential to community health and the need for blood products is constant. As part of our nation’s critical infrastructure, healthy individuals can still donate in areas that have issued shelter in place declarations. The Red Cross follows the highest standards of safety and infection control, and volunteer donors are the only source of blood for those in need. There is no known end date in this fight against coronavirus and the Red Cross needs the help of blood and platelet donors and blood drive hosts to maintain a sufficient blood supply for weeks to come." – American Red Cross
“You can still go out and give blood. We’re worried about potential blood shortages in the future. Social distancing does not have to mean social disengagement.” – U.S. Surgeon General